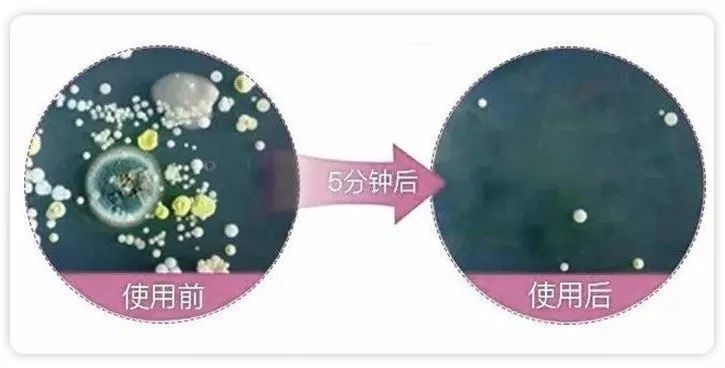

不过说到内衣清洗液产品,可要谨慎了!选的好与否直接关系到身体的健康,有的人直接用肥皂清洗内衣,有的人用洗衣液,有的人用专用的内衣清洗液,哪个好?内衣皂、洗衣液和内衣洗衣液究竟有什么区别呢?
①肥皂:皂基都是偏碱性,在清洗方面有以下特点,第一洗得干净,清洁力度高,更容易漂洗,不足之处就是刺激性大,也容易有细菌残留。适合清洗外衣,衣领,袖口,袜子等脏污比较严重的衣物。
②普通的洗衣液:洗衣液呈液态,渗透性非常好好,能够清洗衣服的袖口、领口等多数死角,易于漂洗,适合清洗所有衣服,也可以清洗内衣,但是抑菌效果不佳。
③专用的内衣清洗液:专用的内衣清洗剂/液,针对人体每天穿的内衣内裤上的分泌物而垂直性研发生产的具有去渍抑菌功能,具有杀菌抗菌的作用。好的内衣液中还会添加纯植物精华,洗的时候不伤手,PH值接近中性,更贴合人体的肌肤,安全无刺激,还具有杀菌消炎的效果。
这样看来,对贴身内衣还是选择专门的内衣清洗剂/液,不仅有清洗作用还有抑菌作用。不过内衣清洗液品牌那么多,应该怎么选呢?
个人认为内衣清洗液要满足至少要满足去除特殊污渍、PH中性、无荧光剂、抑菌(看成分)四大功能,为此我选择了市面上比较火的6款内衣清洗剂,从这4个功能角度做了深度横评,希望可以给到大家帮助。
本次测评的产品来源横跨半个地球,国产、日产、洋货都有,分别是:
①遇见香芬泡沫内衣洗衣液(中国)
②小林内裤清洗剂(日本)
③Walch/威露士有氧洗衣液(中国)
④芳新内衣裤洗衣液(美国)
⑤芝芙莲内衣内裤清洗液(泰国)
⑥蓝宝丝内裤专用洗衣液(德国)

本次测评的6款内衣清洗液,有的标榜浓缩型,滴几滴就能有较丰富的泡沫,但同时泡沫丰富,却不容易漂洗,会相对残留。个人喜欢泡沫少的,方便漂洗。
至于有些人说泡沫少,去污不强,这是误区了,去污能力强弱跟表活剂相关,而发泡原理只是添加了增泡剂而已。
使用感受主要是考虑对手部有没有刺激性,有无过敏现象。

总结看来,美国芳新的泡沫一般,比较好漂洗,其次是遇见香芬。
在使用感受上,威露士有烧手的感觉,不推荐!而芝芙莲的味道跟舒肤佳的极其相像,不怎么好闻。
part2:去污力度内裤本身很容易堆积一些黄色污渍和血渍,所以去污能力是考验内衣洗衣液的重要指标。去污力能力跟表活添加剂相关,但具体还是要看实操效果。
取相同剂量的洗衣液,搓洗带有血渍的抹布,去污效果如下:

通过上图我们看到,遇见香芬对于血渍的清洁能力真的是很好,不但快速,还洗的特别干净,威露士的清洁能力也还不错,但芝芙莲,蓝宝丝,芳新的效果就显得一般了,污渍残留比较明显。
part3:ph酸碱度人体的皮肤最佳PH值为5.5-6,接近于中性,所以ph值越接近这个数值最贴合肌肤。
同时,PH值近中性不伤害精致内衣的面料纤维有抗菌功效保护内衣裤和私密部位的环境健康低泡易漂去污强让内衣裤真正干净,无污渍残留免搓洗!
以下6款pH值测试结果如下:

总结来看,胜出的是遇见香芬,ph值接近于6,其次是芝芙莲,pH值接近于6.1,最让我意想不到的是小林制药,这款内衣洗液在网络上超级火,pH值竟然高达9.2,呈深碱性。
part4:荧光剂测试大部分的洗衣液都在其中添加了荧光增白剂。它是一种化学物质,使用后造成其成分在皮肤和衣物上残留,人体内蓄积,其毒性累积在肝脏或其他重要器官,造成血液系统受损,会削减人体免疫力,潜在致癌因素之一。

所以我们取了相同剂量洗衣液,用荧光灯照射,其中液体呈现蓝色不含荧光剂,无变化的则还有荧光剂。

前文中也提到,内衣上的细菌种类繁多,一款优秀的内衣洗衣液,在除菌抑菌上也必须足够突出。但是菌类这种东西,一是没有显微镜,,二是无法避免外界环境的污染,做不到精准的测量,所以本趴就从抑菌成分上来看啦。
6款内衣洗衣液成分如下:

总得来看,这6款内衣洗衣液,除了必要的表面活性剂成分外,只有蓝宝丝添加了植物杀菌成分香茅醇和香叶醇,其中遇见香芬和蓝宝丝还添加了酶,具有分解、去除污渍的作用。
part6:总结根据6款内衣洗衣液测评来看,市场上的内衣洗衣液确实良莠不齐,有的宣传清洁,但实测效果却十分一般。有的宣传亲肤,但ph值却差强人意,甚至有些大品牌也意外爆雷,比如小林制药,碱性极强,刺激性还是比较大的。
综合评分10星制:
遇见香芬:★★★★★★★★8颗星
芝芙莲:★★★★★★★★8颗星
威露士:★★★★★★★7颗星
蓝宝丝:★★★★★★6颗星
小林制药:★★★★★5颗星
美国芳新:★★★★★5颗星
本次测评仅供参考,如有更多好的产品,欢迎评论区爆料,我们期待能在“评论区挖到宝”系列。返回搜狐,查看更多